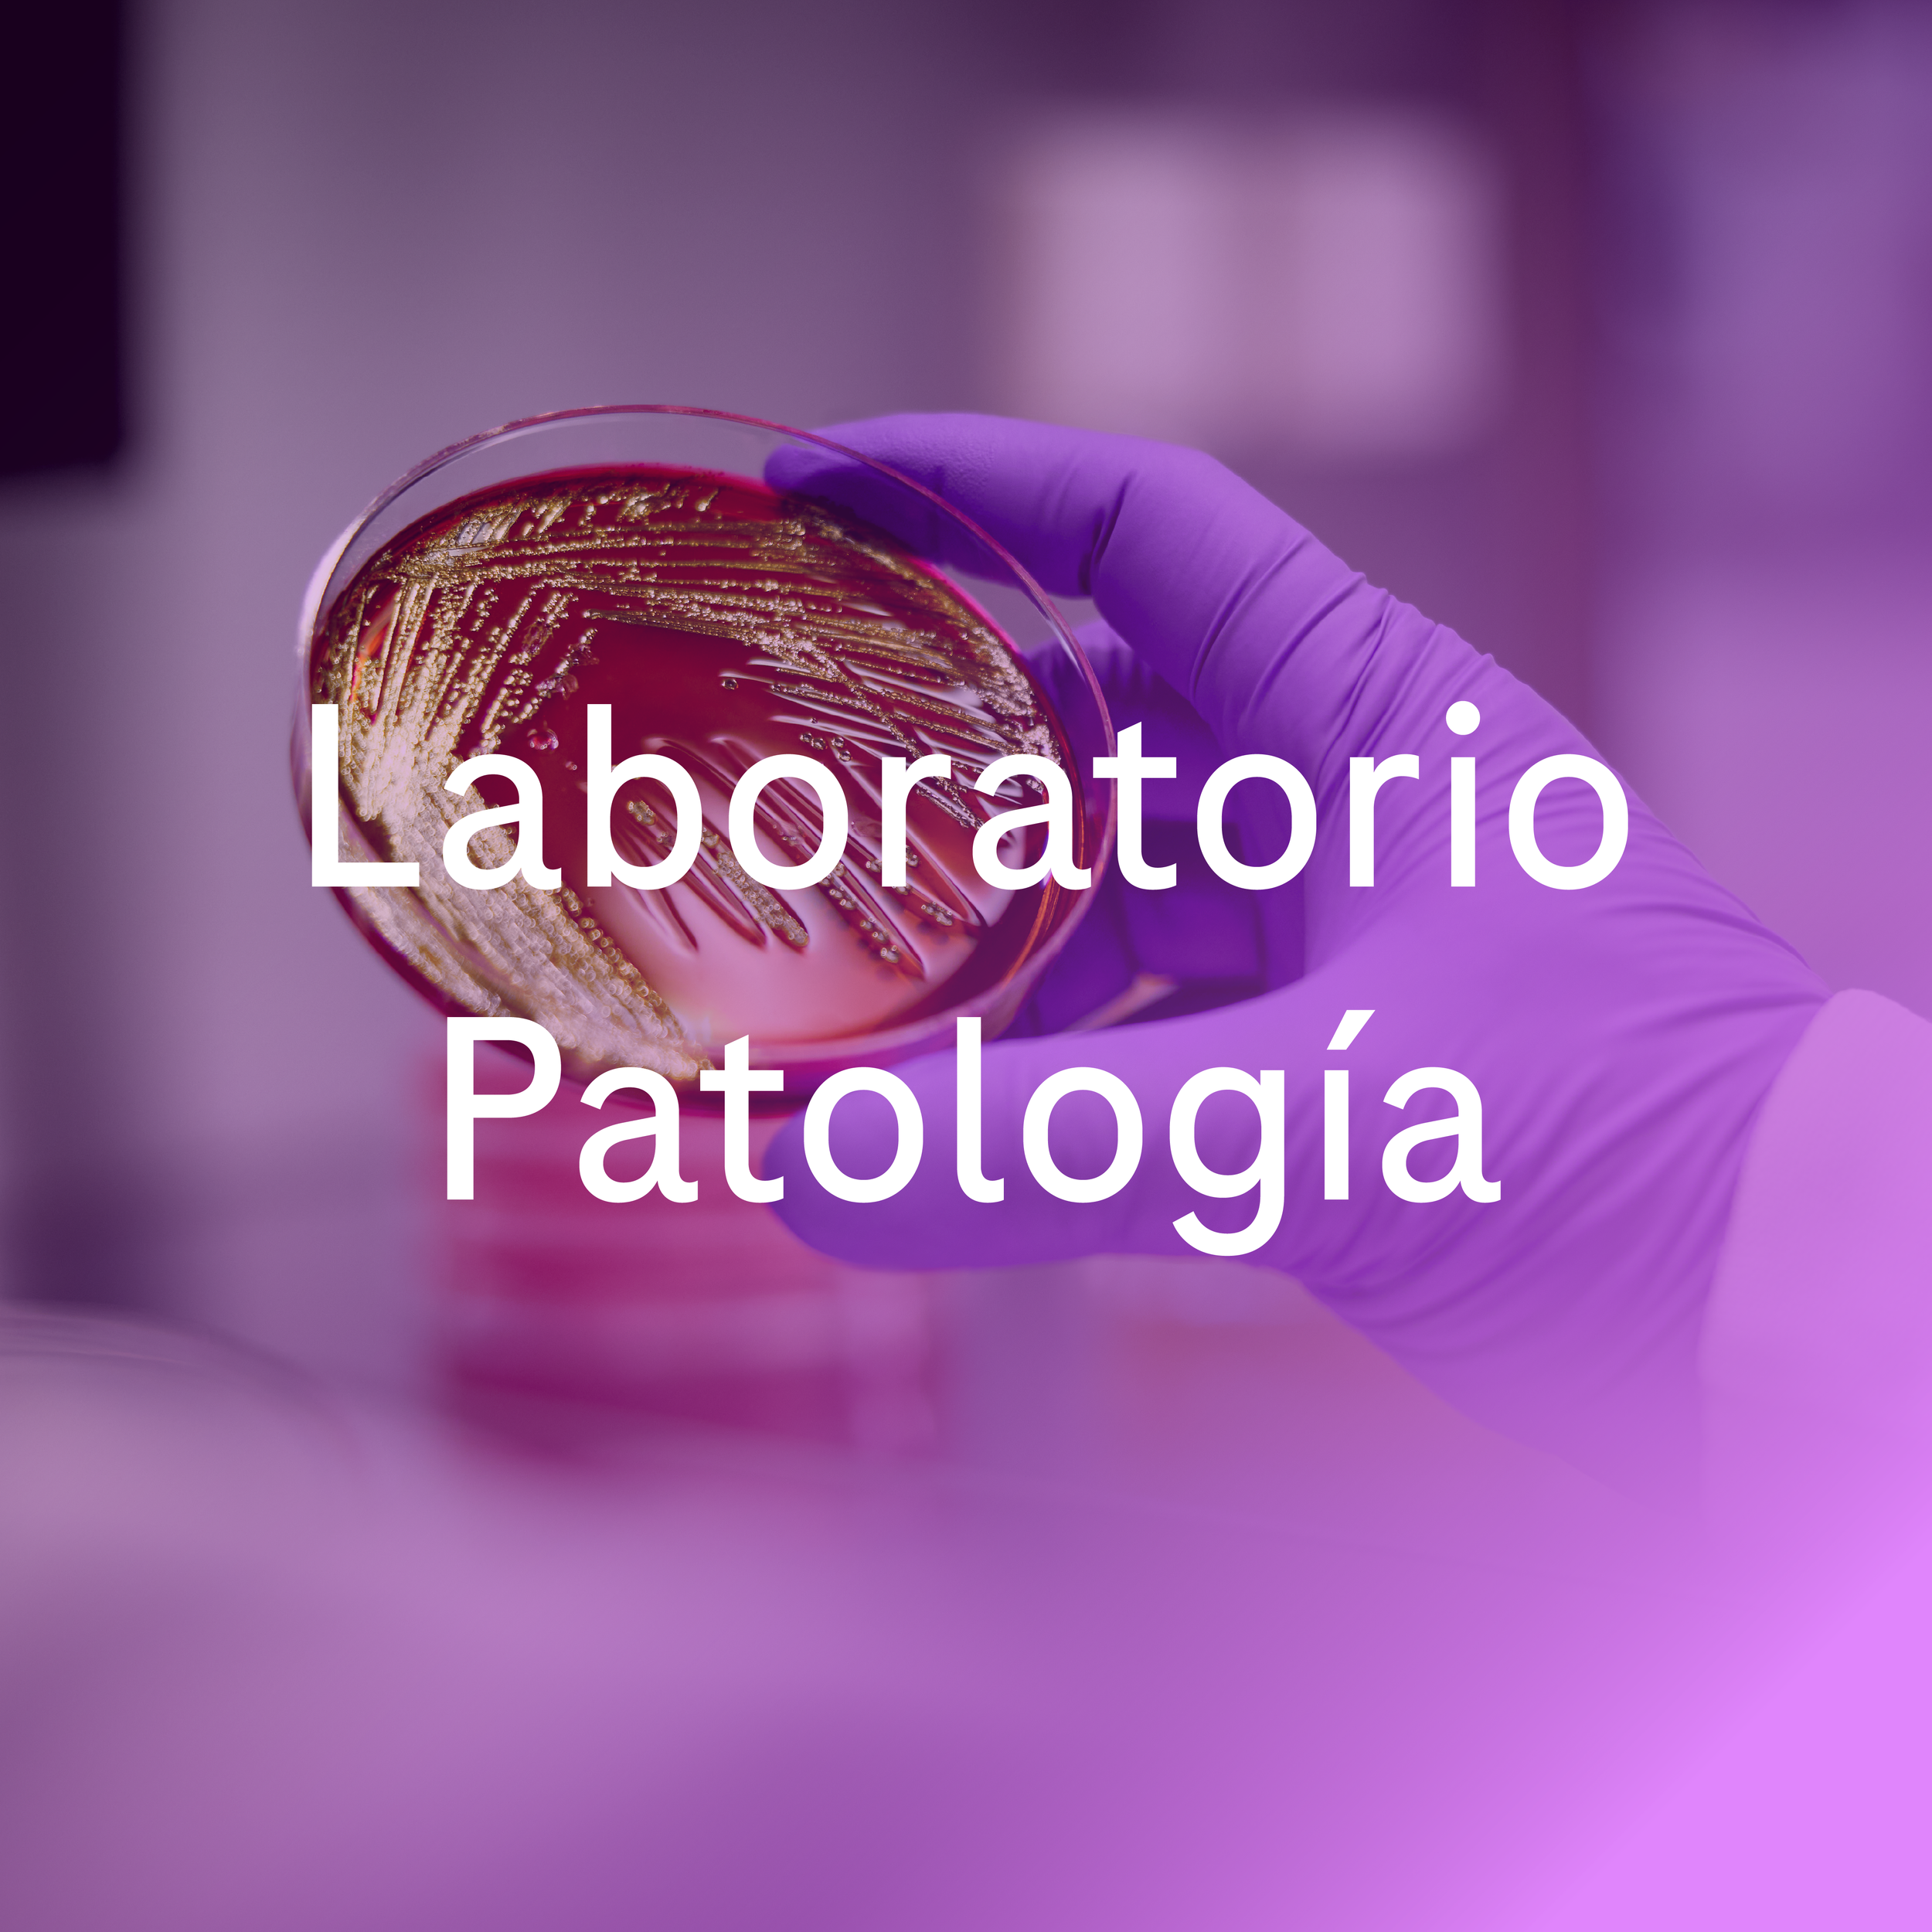

Nuestros servicios
Tómate un minuto para escribir una introducción corta, agradable y directa. Si vendes algo, usa este espacio para describirlo en detalle y decirnos por qué deberíamos comprarlo. Aprovecha tu creatividad. ¡Tú puedes!
Elegir un paquete
Testimonios

Conoce nuestros servicios
-
¿Qué debemos saber sobre los servicios que ofreces? Las mejores descripciones generan más ventas.
-
¿Qué debemos saber sobre los servicios que ofreces? Las mejores descripciones generan más ventas.
-
¿Qué debemos saber sobre los servicios que ofreces? Las mejores descripciones generan más ventas.